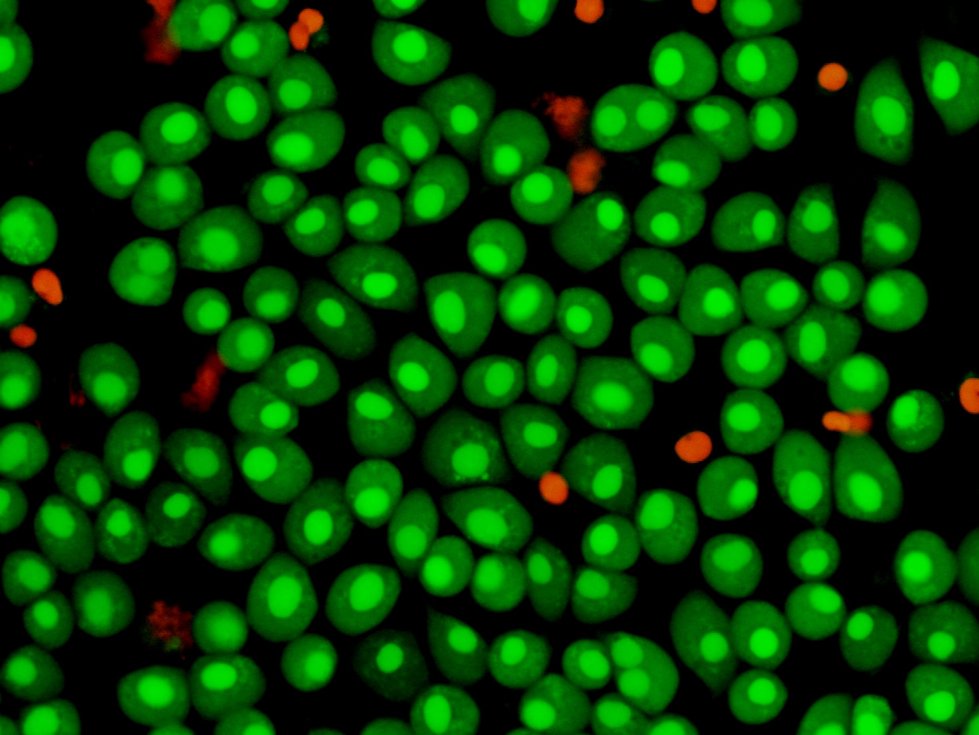
Киборги внутри нас? Модифицированные учеными клетки станут грозной силой в борьбе с опасными заболеваниями Киборги внутри нас? Модифицированные учеными клетки станут грозной силой в борьбе с опасными заболеваниями

Победители конкурсов РФФИ для ведущих молодежных коллективов нередко признаются: не очень верили, что их проект оценят по достоинству. Но перспективность исследований, потенциал их авторов не ускользают от внимания опытных экспертов фонда. Этими качествами в полной мере обладает и работа, о которой мы рассказываем сегодня...
Чего только не делают ученые с клетками! Свойства, которые они придают “живым кирпичикам”, помогут, в частности, разрабатывать уникальные биотехнологии для лечения тяжелых заболеваний. В лаборатории бионанотехнологии и биоматериалов Казанского (Приволжского) федерального университета (КФУ) под руководством доктора биологических наук доцента Равиля Фахруллина с помощью наночастиц создают магнитные клетки-киборги. Исследование поддержано грантом РФФИ. О том, что представляют собой “клетки-киборги” и как удалось выйти на такую, с фантастическим уклоном тему, ученый рассказал корреспонденту “Поиска”.
- Наша лаборатория занимается магнитно-модифицированными клетками с 2008 года, - говорит Равиль Фаридович. - В англоязычной литературе существует термин “cell surface engineering” - инженерия клеточной поверхности. Это научное направление занимается изменением именно поверхности живых клеток. Делается это с помощью функциональных наноматериалов: наночастиц, полимерных пленок, нанотрубок и всевозможных их комбинаций, что позволяет усилить или модифицировать полезные свойства клеток, а также собирать из них многоклеточные структуры. Подобно тому, как из кубиков составляют разные сооружения. Можем присоединять их к различным поверхностям, более крупным частицам, перемещать в пространстве или снабжать питательными веществами из наноконтейнеров. Такие наномодифицированные “кирпичики” мы называем “клетками-киборгами” по аналогии с героями фантастических фильмов. В отличие от киношных киборгов (искусственных механизмов, но с живой кожей) наши представляют собой живые организмы с искусственным покрытием. Наиболее значимые из наших предыдущих исследований были направлены на создание методов магнитной модификации (“функционализации”) микробных клеток и искусственных многоклеточных систем.
Мы использовали магнитные микробные клетки для разработки биосенсорных систем, например, оценки токсичности. Для этого к клеточным стенкам прикрепляли специальные наночастицы, после чего клетки становились магнитно-восприимчивыми, то есть притягивались к постоянному магниту. А нанесение многослойной полимерной “шубы” на поверхность дрожжей позволило нам получить многоклеточные “цитозомы” - микрочастицы, состоящие из живых клеток и внешне напоминающие примитивные колониальные организмы. Уже тогда мы задумали применять на человеческих клетках методы магнитной модификации, опробованные нами на микробах. Использование магнитного поля открывает возможность создавать прототипы биологических тканей.
Тканевая инженерия - сейчас одно из наиболее перспективных направлений в биомедицине. Результаты исследований в этой области позволят получать новые искусственные ткани и даже органы, которые можно будет пересаживать пациентам. Со временем трансплантологи смогут заменить ими донорские материалы. Снимутся все проблемы с биосовместимостью. Сегодня эти технологии находятся в основном на стадии лабораторных испытаний, но в будущем займут достойное место в медицинской практике.
- Что представляют собой магнитно-модифицированные клетки и как их “изготавливают”?
- Наши исследования направлены на получение, а также определение характеристик магнитных “клеток-киборгов”, то есть таких клеток человека, к поверхности которых прикреплены наночастицы с особыми свойствами. Такая модификация клеток известна достаточно давно, и основное ее преимущество в том, что клетками можно “управлять на расстоянии” с помощью магнитного поля. Этот метод очень удобен: можно использовать магниты для укладки клеток в многослойные конструкции.
Многие исследовательские группы довольно длительное время применяют методы, при которых клетки снабжаются магнитными метками - для этого в их “внутренности” тем или иным способом вводят магнитные наночастицы. Это занимает немало времени, а главное - крошечные частицы внутри клеток могут существенно повлиять на их жизнеспособность. Сегодня еще нельзя с уверенностью говорить о возможных долговременных эффектах, вызываемых их внедрением в живые структуры.
Новизна нашего подхода состоит в том, что мы присоединяем наночастицы к поверхности клеточных мембран, они практически не проникают внутрь клеток. Таким способом мы сводим к минимуму возможность отрицательного воздействия наноматериалов на ферменты и генетический аппарат. Как результат, магнитные “клетки-киборги” способны к росту и делению так же эффективно, как и интактные (то есть исходные, не магнитные). Кроме того, используемый нами метод магнетизации требует значительно меньшего времени для того, чтобы пометить клетки: наночастицы присоединяются к ним в физиологических условиях за 10-15 минут, тогда как альтернативные методы требуют более длительного периода (до 72 часов).
В отличие от микробов клетки млекопитающих не защищены массивной клеточной стенкой, что существенно затрудняет процесс модификации их поверхности. Наночастицы должны обладать коллоидной стабильностью в физиологических средах. В рамках проекта, отмеченного грантом РФФИ (которым поддерживаются работы, выполняемые ведущими молодежными коллективами), мы синтезируем такие частицы, стабилизируя биосовместимыми полимерами, и они способны присоединятся к клеткам. В результате такие клетки, покрытые наночастицами, ведут себя подобно микроскопическим магнитикам, их можно сконцентрировать и удерживать в пространстве, например, с помощью простейшего постоянного магнита. Сегодня мы используем такие живые структуры с дополнительными свойствами для создания искусственных многослойных клеточных кластеров - прототипов тканей. Например, можем наслаивать клетки друг на друга, что позволяет в какой-то степени воссоздать структуру естественного материала. Кроме того, методы, которые мы разрабатываем, могут найти применение в тех случаях, когда требуется обеспечить направленную доставку одного типа клеток в определенный орган человека, где необходимо создать их высокую концентрацию.
- Чтобы выполнять такие сложные исследования, нужны, мне кажется, большая группа специалистов и хорошее оборудование. Все это у вас есть?
- Наш коллектив нельзя назвать большим: включая меня, в нем три научных сотрудника, аспирант, магистрант и два студента. Но мы стараемся работать не хуже, чем многочисленные группы. Мои сотрудники - специалисты в области клеточной биологии, физико-химических методах исследований, микроскопии. Каждый из них задействован в проекте, выполнение которого предусматривает синтез наночастиц, изучение их характеристик и токсичности, эксперименты по магнитной модификации клеток.
Мы работаем в Казанском университете, одном из старейших вузов страны. В последние годы КФУ существенно обновил парк лабораторного оборудования, теперь у нас есть возможность использовать многие современные методы исследований. Самое ценное в нашем коллективе - отношения между людьми, основанные на взаимопонимании, уважении, поддержке. Каждый занимается той работой, которая ему интересна. Я, как руководитель, определяю общее направление исследований, однако любой из членов коллектива самостоятельно решает многие текущие вопросы, предлагает новые темы. Исследования по наномодификации клеток требуют качественной подготовки сотрудника, он должен владеть современными методами исследований. Кроме того, нужно быть очень аккуратным и терпеливым: работа с малыми объектами невозможна без трепетного к ним отношения. В общем, секрет нашего успеха - это люди. У нас есть публикации в престижных журналах, победы в различных специализированных конкурсах. Мы часто обмениваемся информацией с коллегами, в том числе зарубежными, без такого обмена опытом и знаниями не обойтись современному ученому. Ну и, конечно, работаем в тесном контакте с другими исследовательскими группами нашего университета.
- Какую-то часть работы вы уже сделали?
- Практически завершен первый этап проекта. Синтезировали наночастицы, установили их характеристики. Провели магнитную модификацию изолированных клеток человека. Выбрали модельные клетки, магнетизированные с помощью наночастиц. Определили экспериментальные условия для их оптимальной магнетизации. Это рутинная, но необходимая работа: нужно определить концентрации реагентов, время инкубации и многое другое. Кроме того, провели исследования по оценке токсичности магнитных наночастиц по отношению к клеткам и обнаружили, что магнитная модификация не оказывает негативного воздействия на их жизнедеятельность. Результаты своих исследований уже отправили для публикации в один из профильных международных журналов.
- Что планируете сделать на средства гранта?
- Грант РФФИ дал нам возможность провести исследования с использованием культур клеток млекопитающих. Испытания в области клеточной биологии дорогостоящие. Расходные материалы, реактивы, питательные среды для поддержания культур клеток человека стоят значительно дороже, чем аналогичные материалы для микробных клеток. На полученные средства закупим также оборудование для изучения влияния наночастиц на жизнеспособность клеток. Словом, фонд оказал существенную поддержку нашим исследованиям.
Второй этап проекта будет посвящен созданию многослойных многоклеточных кластеров, имитирующих ткани человека. Особый интерес у нас вызывает создание материалов, имитирующих “кружево” легкого человека. Мы планируем разрабатывать и другие модели.
- Каковы перспективы использования магнитно-модифицированных клеток?
- Основная задача нынешнего проекта - создание методологии магнетизации клеток человека. Важно, чтобы ее можно было быстро и легко применять в клиниках. Мы рассчитываем, что результаты наших исследований станут нужными и другим группам ученых, работающим в этом направлении. Предложенные нами методы универсальны, их можно использовать для любого типа клеток. Это позволит применять магнитные “киборги” в конструировании органов и тканей, направленной доставке “терапевтических” клеток, а также в магнитно-резонансной томографии.
Мы продолжим исследования по разработке новых методов инженерии клеточной поверхности, в том числе по магнитной модификации клеток. Заинтересованы в конструировании многоклеточных структур с необычной морфологией, а также в создании наночастиц, которые кроме магнитной функции обладали бы и другими полезными свойствами, например защитными.
Фирюза ЯНЧИЛИНА
Фото из архива лаборатории и Р.Фахруллина
На снимках: 1. Электронная микрофотография магнитной клетки; 2. Магнитные клетки колонизируют субстрат под воздействием магнитного поля; 3. Жизнеспособность магнитных клеток (зеленые - живые, красные - мертвые).